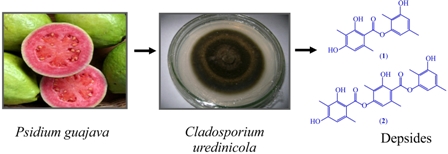

vol. 23, No. 8, 2012, p. 1409-1576
There Is No Future without Good Primary Education
"Water dropping day by day wears the hardest rock away". This popular saying should enlighten and guide the actions of all those committed to improving the educational level and reducing truancy in Brazilian schools.
Sometimes, we seem to forget that from 100 students who start primary school, 44 make it to high school and only 12 go to college. Still worse is the fact that from those 12, not all manage to graduate and many exceed the regular periods of their courses.
(Read more at Editorial)
Iron(III) Porphyrin Covalently Supported onto Magnetic Amino-Functionalized Nanospheres as Catalyst for Hydrocarbon and Herbicide Oxidations
Joicy S. dos Santos; André L. Faria; Patrícia M. da Silva Amorin; Franco M. La Luna; Kely L. Caiado; Débora O. C. e Silva; Patrícia P. C. Sartoratto; Marilda D. Assis
How to cite this article
This work describes a new magnetic catalyst composed of an ironporphyrin, 5,10,15,20-tetrakis(pentafluorophenyl) porphyrin iron(III) chloride, FeTFPP, covalently immobilized onto magnetic maghemite nanospheres covered with aminofunctionalized silica. The catalyst can be easily recovered and washed after reaction through application of an external magnetic field, which favors its reuse. This catalytic system proved to be efficient and selective for hydrocarbon oxidation, specially R(+)-limonene, a compound present in orange peels and in the herbicide simazine, frequently used on sugar cane crops. Details are discussed on page 1411.
https://dx.doi.org/10.1590/S0103-50532012005000005
Editorial J. Braz. Chem. Soc. 2012, 23(8), 1409-1410
Articles J. Braz. Chem. Soc. 2012, 23(8), 1411-1420
Iron(III) Porphyrin Covalently Supported onto Magnetic Amino-Functionalized Nanospheres as Catalyst for Hydrocarbon and Herbicide Oxidations
Joicy S. dos Santos; André L. Faria; Patrícia M. da Silva Amorin; Franco M. La Luna; Kely L. Caiado; Débora O. C. e Silva; Patrícia P. C. Sartoratto; Marilda D. Assis
How to cite this article

This work describes the covalent immobilization of an ironporphyrin, 5,10,15,20-tetrakis(pentafluorophenyl)porphyrin iron(III) chloride (FeTFPP), onto maghemite/silica magnetic nanospheres covered with aminofunctionalized silica and its use as catalyst for hydrocarbon and herbicide (simazine) oxidations
https://dx.doi.org/10.1590/S0103-50532012005000005
J. Braz. Chem. Soc. 2012, 23(8), 1421-1428
Comparison of Different Pre-treatment Procedures for the Determination of Chromium in Crude Oil Samples by GF AAS
Helen M. Pessoa; Fernanda H. Lyra; Eustáquio Vinicius R. de Castro; Reinaldo C. de Campos; Maria Tereza W. D. Carneiro; Geisamanda P. Brandão
How to cite this article

Cr absorption signal obtained by DS-GF AAS of 0.760 mg of crude oil sample without pre-treatement (red - Cr atomic absorption signal; blue - background signal)
https://dx.doi.org/10.1590/S0103-50532012005000004
J. Braz. Chem. Soc. 2012, 23(8), 1429-1436
PAHs in Cultured Mussels Perna perna from a Southeastern Brazilian Bay
Renato V. Yoshimine; Renato S. Carreira
How to cite this article

The occurrence of polycyclic aromatic hydrocarbons (PAHs) in mussels (Perna perna) cultured in farms from Ilha Grande Bay (Rio de Janeiro State, Brazil) was evaluated for the first time. The levels of PAHs were generally low and below the threshold concentrations recommended for human consumption of shellfish. The results also revealed reasonable good local environmental conditions
https://dx.doi.org/10.1590/S0103-50532012005000003
J. Braz. Chem. Soc. 2012, 23(8), 1437-1440
Lanthanide Nitrates as Lewis Acids in the One-Pot Synthesis of 1,2,4-Oxadiazole Derivatives
Juliana A. Vale; Wagner M. Faustino; Davila de S. Zampieri; Paulo J. S. Moran; José A. R. Rodrigues; Gilberto F. de Sá
How to cite this article

Lanthanide nitrates [Ln(NO3)3] acting as catalyst in direct one-pot synthesis of 3-benzoyl- and 3-acetyl-1,2,4-oxadiazoles derivatives from aromatic ketones with electron-donating (EDG) and electron-withdrawing groups (EWG)
https://dx.doi.org/10.1590/S0103-50532012005000002
J. Braz. Chem. Soc. 2012, 23(8), 1441-1449
Simultaneous Quantification of Lycopene, β-Carotene, Retinol and α-Tocopherol in Plasma after a Simple Extraction Procedure: Stability Study and Application to Human Volunteers
Mariele F. Charão; Angela M. Moro; Natália Brucker; Rachel P. Bulcão; Marília Baierle; Fernando Freitas; Juliano Durgante; Sabrina Nascimento; Guilherme B. Bubols; Paulo H. Saldiva; Denise Bohrer; Solange C. Garcia
How to cite this article

The described method consists of a rapid and simple liquid-liquid extraction procedure and posterior quantification by high-performance liquid chromatography (HPLC) with Vis/fluorescence detection. It was shown to be a sensitive method for the simultaneous determination of lycopene, β-carotene, retinol and α-tocopherol in human plasma and can be utilized in routines of clinical laboratories
https://dx.doi.org/10.1590/S0103-50532012005000001
J. Braz. Chem. Soc. 2012, 23(8), 1450-1459
Kinetic Analytical Method for Determination of Uric Acid in Human Urine using Analyte Pulse Perturbation Technique
Nataša D. Pejić; Jelena P. Maksimović; Slavica M. Blagojević; Slobodan R. Anić; Željko D. Čupić; Ljiljana Z. Kolar-Anić
How to cite this article

The kinetic methods based on the potentiometric monitoring of the concentration perturbations of the both the Bray-Liebhafsky oscillatory reaction in a stable non-equilibrium stationary state and Dushman reaction in a steady state, are described. The methods are utilized for determination of uric acid in human urine samples
https://dx.doi.org/10.1590/S0103-50532012005000006
J. Braz. Chem. Soc. 2012, 23(8), 1460-1468
Optimization of an Analytical Protocol for the Extraction, Fractionation and Determination of Aromatic and Aliphatic Hydrocarbons in Sediments
Vânia R. Ferreira; Cindy D. Gouveia; Cesar A. da Silva; Andreia N. Fernandes; Marco T. Grassi
How to cite this article

PAH concentrations recovered from certified reference sediment (NWRI EC-3). Vertical bars represent the standard deviation (n = 3) for the recovered and for the certified values (n = 3)
https://dx.doi.org/10.1590/S0103-50532012005000010
J. Braz. Chem. Soc. 2012, 23(8), 1469-1475
Spectrophotometric Evaluation of the Behavior of Disperse Red 1 Dye in Aqueous Media and its Interaction with Calf Thymus ds-DNA
Carolina V. Uliana; Gustavo S. Garbellini; Hideko Yamanaka
How to cite this article

Studies of the solubility of the model dye disperse red 1 (DR1) in aqueous solutions, its determination in water samples and the interaction of the dye with calf thymus ds-DNA were performed using UV-Vis spectrophotometry
https://dx.doi.org/10.1590/S0103-50532012005000009
J. Braz. Chem. Soc. 2012, 23(8), 1476-1487
Currently Used Pesticides in Water Matrices in Central-Western Brazil
Elisângela N. Nogueira; Eliana F. G. C. Dores; Alício A. Pinto; Ricardo S. S. Amorim; Maria L. Ribeiro; Carolina Lourencetti
How to cite this article

Currently used pesticides in water matrices in Central-Western Brazil reveal a higher diversity of compounds and frequency of detection in rain water than in surface and groundwater samples and point to the risk of pesticide contamination in important headwater streams in the study areas
https://dx.doi.org/10.1590/S0103-50532012005000008
J. Braz. Chem. Soc. 2012, 23(8), 1488-1500
Anionic Chromogenic Chemosensors Highly Selective for Fluoride or Cyanide Based on 4-(4-Nitrobenzylideneamine)phenol
Celso R. Nicoleti; Vanderléia G. Marini; Lizandra M. Zimmermann; Vanderlei G. Machado
How to cite this article

4-(4-Nitrobenzylideneamine)phenol is used in the study of anionic chromogenic chemosensors in acetonitrile allowing the highly selective detection of F- and CN-. These chemosensors are based on acid-base and on indicator displacement strategies
https://dx.doi.org/10.1590/S0103-50532012005000007
J. Braz. Chem. Soc. 2012, 23(8), 1501-1505
Comparison of the n-Alkanes and Polycyclic Aromatic Hydrocarbons Concentrations in the Atmosphere during the Preparation of Warm and Hot Mixtures Asphalt for Pavements
Rosângela Motta; Pérola C. Vasconcellos; Liedi Bernucci; Simone G. Avila; Talita Cornetti
How to cite this article

Warm mix asphalt (WMA) is a new paving technology produced with temperature around 30 °C lower than conventional hot mix asphalt (HMA). Due to the reduction of temperature, less n-alkanes and polycyclic aromatic hydrocarbons (PAH) are generated during the production of WMA than HMA
https://dx.doi.org/10.1590/S0103-50532012005000011
J. Braz. Chem. Soc. 2012, 23(8), 1506-1514
Quantitative Chemical Profile and Multivariate Statistical Analysis of Alembic Distilled Sugarcane Spirit Fractions
Felipe A. T. Serafim; Carlos A. Galinaro; Alexandre A. da Silva; Silmara F. Buchviser; Eduardo S. P. do Nascimento; Fernando V. Novaes; Douglas W. Franco
How to cite this article

During the alembic distillation process, the sugarcane spirit is separated into three different fractions which presented differences among their quantitative chemical profile. In this work was suggested a quantitative chemical model for it in order to support the standardization of this production step
https://dx.doi.org/10.1590/S0103-50532012005000015
J. Braz. Chem. Soc. 2012, 23(8), 1515-1522
A LED Based Photometer for Solid Phase Photometry: Zinc Determination in Pharmaceutical Preparation Employing a Multicommuted Flow Analysis Approach
Tuanne R. Dias; Boaventura F. Reis
How to cite this article

A LED (light emitting diode) based photometer for solid phase photometry coupled to a multicommuted flow analysis approach forming a downsized setup that is designed for zinc determination in pharmaceutical products
https://dx.doi.org/10.1590/S0103-50532012005000014
J. Braz. Chem. Soc. 2012, 23(8), 1523-1535
Synthesis, Electrochemical, Spectrophotometric and Potentiometric Studies of Two Azo-Compounds Derived from 4-Amino-2-Methylquinoline in Ethanolic-Aqueous Buffered Solutions
Mona A. El-Attar; Iqbal M. Ismail; Mohamed M. Ghoneim
How to cite this article

Two azo-compounds derived from 4-amino-2-methylquinoline were synthesized and characterized. Their electrode reaction pathways were elucidated and discussed. Dissociation and stability constants of the examined azo-derivatives and stoichiometry of their complexes with some transition metal ions were determined
https://dx.doi.org/10.1590/S0103-50532012005000013
J. Braz. Chem. Soc. 2012, 23(8), 1536-1542
A Peroxotungstate-Ionic Liquid Brush Assembly: an Efficient and Reusable Catalyst for Selectively Oxidizing Sulfides with Aqueous H2O2 Solution in Neat Water
Xianying Shi; Wenjuan Ma; Hui Ou; Xiaoyan Han; Congmin Lu; Yan Chen; Junfa Wei
How to cite this article

An environmentally-friendly procedure was developed for selective oxidation of sulfides at room temperature using 30 wt.% hydrogen peroxide as terminal oxidant and water as sole solvent. The catalyst is easily recovered post-reaction (via simple filtration) and reused at least eight times without a noticeable loss of activity
https://dx.doi.org/10.1590/S0103-50532012005000012
J. Braz. Chem. Soc. 2012, 23(8), 1543-1550
Kinetics and Mechanism of Chlorate-Chloride Reaction
Rafaela T. P. Sant'Anna; Cristina M. P. Santos; Guilherme P. Silva; Ricardo J. R. Ferreira; André P. Oliveira; Carlos E. S. Côrtes; Roberto B. Faria
How to cite this article

A saturation profile for chloride concentration was found in a kinetic study for the chlorate-chloride reaction, suggesting the formation of Cl2O32- intermediate. The proposed mechanism was able to reproduce the experimental behavior
https://dx.doi.org/10.1590/S0103-50532012005000017
J. Braz. Chem. Soc. 2012, 23(8), 1551-1557
Evaluation of Herbicidal Potential of Depsides from Cladosporium uredinicola, an Endophytic Fungus Found in Guava Fruit
Lívia S. de Medeiros; Olívia M. Sampaio; Maria Fátima das G. F. da Silva; Edson Rodrigues Filho; Thiago André M. Veiga
How to cite this article
Two natural depsides, 2,4-dihydroxy-3,6-dimethylbenzoate (1) and 3-hydroxy-2,5-dimethylphenyl 4-[(2,4-dihydroxy-3,6-dimethylbenzoyl) oxy]-2-hydroxy-3,6-dimethylbenzoate (2), were isolated from Cladosporium uredinicola and their effects on various steps of photosynthesis were investigated
https://dx.doi.org/10.1590/S0103-50532012005000018
J. Braz. Chem. Soc. 2012, 23(8), 1558-1562
Cytotoxic Cordiaquinones from the Roots of Cordia polycephala
Hozana Patrícia S. Freitas; Ana Isabel V. Maia; Edilberto R. Silveira; José Delano B. Marinho Filho; Manoel O. Moraes; Cláudia Pessoa; Letícia V. Costa Lotufo; Otília Deusdênia L. Pessoa
How to cite this article

The chemical investigation of the roots of Cordia polycephala resulted in the isolation of two new terpenoid naphtoquinones, named as cordiaquinones N and O. Both compounds showed cytotoxic effects with IC50 values in the range of 1.2 to 3.4 μmol L-1
https://dx.doi.org/10.1590/S0103-50532012005000019
J. Braz. Chem. Soc. 2012, 23(8), 1563-1569
Photocatalytic Degradation of Camphor by Suspended and Immobilized Photocatalysts
Carla Sirtori; Adriane M. de Freitas; Sérgio Toshio Fujiwara; Patricio Peralta-Zamora
How to cite this article

Immobilized forms of TiO2 permit almost total photocatalytic degradation of camphor in aqueous solution, including high mineralization degrees
https://dx.doi.org/10.1590/S0103-50532012005000020
J. Braz. Chem. Soc. 2012, 23(8), 1570-1576
A Quantitative Method using Near Infrared Imaging Spectroscopy for Determination of Surface Composition of Tablet Dosage Forms: an Example of Spirolactone Tablets
Renato L. Carneiro; Ronei J. Poppi
How to cite this article

The homogeneity of the components of a tablet was investigated using near infrared (NIR) imaging spectroscopy. Left side of the graphical abstract presents the chemometric technique used to find concentration maps of excipients and active pharmaceutical ingredient. Right side of the figure shows a tablet and the distribution of compounds in the tablet surface
https://dx.doi.org/10.1590/S0103-50532012005000022
Online version ISSN 1678-4790 Printed version ISSN 0103-5053
Journal of the Brazilian Chemical Society
JBCS Editorial and Publishing Office
University of Campinas - UNICAMP
13083-970 Campinas-SP, Brazil
Free access










